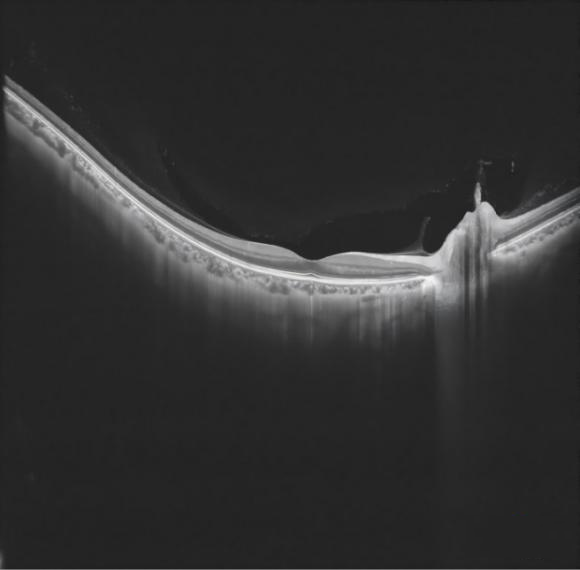

| Holoeye空间光调制器 | ALPAO高速变形镜 | 波前分析仪Phasics | 自适应光学系统 | 数字微反射镜 DMD 数字微镜器件 | 光学元件器件DOE |
| 光刻仪 |
| 飞秒激光器 | 皮秒激光器 | 自相关仪 | 超短脉冲测量仪Frog | 超快激光器件 |
| 高功率连续波OPO | 高功率光纤激光器 | Qioptiq NANO 激光器 | 低噪声窄线宽激光器 | 可调谐激光器 | 半导体激光器和放大器 | SLD和ASE宽带光源 | 双波长输出氦氖激光器 |
| QIOPTIQ光纤耦合半导体激光器 | Diode & DPSS_qioptiq | 激光驱动白光光源 | 等离子体宽带光源 | 单色仪 | 光谱仪 | 光栅 | 辐射计 | 防嗮系数分析 | Optogma固体激光器 | Solarlight | 波长选择器 |
| 激光准直仪 | 红外激光观察镜 | 激光功率能量计 | 光学斩波器 | 光束质量分析仪 | 位敏探测器 | 红外相机 | O/E转换模块探测器 TIA-525S |
| 太赫兹相机及源 | 太赫兹探测器 | 太赫兹元器件及晶体 | 太赫兹光谱仪 | 太赫兹功率计 |
| Optiphase | 微光MOI |
| 普克尔盒/Pockels Cells | 电光调制器/Electro-Optics Modulators | 法拉第隔离器/Faraday Isolators | SESAM半导体可饱和吸收镜 | 探测器 | EOT高速光电探测器 | 其他未分类 |
| 电化学ECV 扩散浓度 | 接触电阻测量仪 | 四点探针测试仪 | 少子寿命测试仪 |
| 平行光管 |
| 光纤跳线及配件 | 无源器件 |

产品概述
Adams-DAQ1G是一款8bit双通道高速波形数字化仪卡,采用简化信号幅度控制与 Trigger 电路设计,实现高速、高保真、同步、低噪声性能,性能表现优于主流 1G 采集卡,完美适配 OCT、激光雷达、高频超声等对速度、精度、时序要求严苛的场景,支持 OEM 嵌入式集成。
Adams_DAQ1G 目前已经在Intalight 赛炜(全球高端光学眼科器械平台型企业)研发的光学相干断层扫描(OCT) Model:MT700中采用。
优势特点
高采样率 1GS/s能接住高速光电探测器、高速超声、射频、激光雷达的输出,适配 OCT 这种超高速瞬态信号。 | 高性价比 8bit满足绝大多数高速应用需求,成本更低、数据量更小、传输压力小 | 强兼容性 Gen2是最成熟、最普及的版本,支持大多数机器,兼容性强,成本低,功耗低,适配采集率与采集精度。 | 无丢点采集 1G深度可完整支撑1秒1GS/s 无丢点采集,有效抵御系统与存储延迟,适配 OCT等长时程、高密度、大深度高速采集场景。 |
其他特点 ▪数据吞吐率高 ▪1ns高精度触发 ▪宽输入量程 ▪有效位数多 ▪支持Windows ▪软件开发工具包支持C/C++、C#等
| 应用 ▪光学相干层析(OCT) ▪超声与涡流无损检测/无损评估 ▪激光雷达及雷达/射频信号记录 ▪TB 级存储示波器 ▪高分辨率示波器 ▪多通道瞬态记录
|
技术参数
| 参数 | 描述 |
|---|---|
| 采样率 | 1GS/s |
| 采样通道数 | 2 |
| 带宽 | 450MHz |
| 采样精度 | 8bit |
| 无杂散动态范围SFDR | >53dBc |
| 有效位数ENOB | 7.5bit |
| 数据吞吐率 | ≥2GB/s |
| 接口 | PCIe Gen2 x8 |
| 输入量程 | ±200mV~±1.0V |
| 每通道存储深度 | 1G |
| 触发输入 | 2路 |
| 输入精度 | 1ns |
| 输入阻抗及类型 | 50Ω,DC |
| 输入接口 | SMA |
使用条件
| 要求 | 参数 | 描述 |
|---|---|---|
| 环境要求 | 工作温度 | 0-65℃ |
| 存储温度 | -20-75℃ | |
| 温湿度测试 | 在 60℃,93%湿度下存储 48 小时,湿热存储前后性能没有显著变化 | |
| 硬件要求 | 供电电压 | +12 DC |
| 主机接口 | 需配备 PCIe Gen2 x8 及以上规格 PCIe 插槽的台式机/工控机/服务器 | |
| 存储配置 | 建议配备高速固态硬盘(SSD),满足≥2 GB/s 数据吞吐率的实时存储需求。 | |
| 软件要求 | 操作系统 | Windows 操作系统; 针对二次开发需求,提供支持C/C++、C#等多语言的 SDK 开发工具包。 |
原理

性能
Adams-DAQ1G 采集卡在应用中图像质量展示
|
|
| |||||||||||||||||||